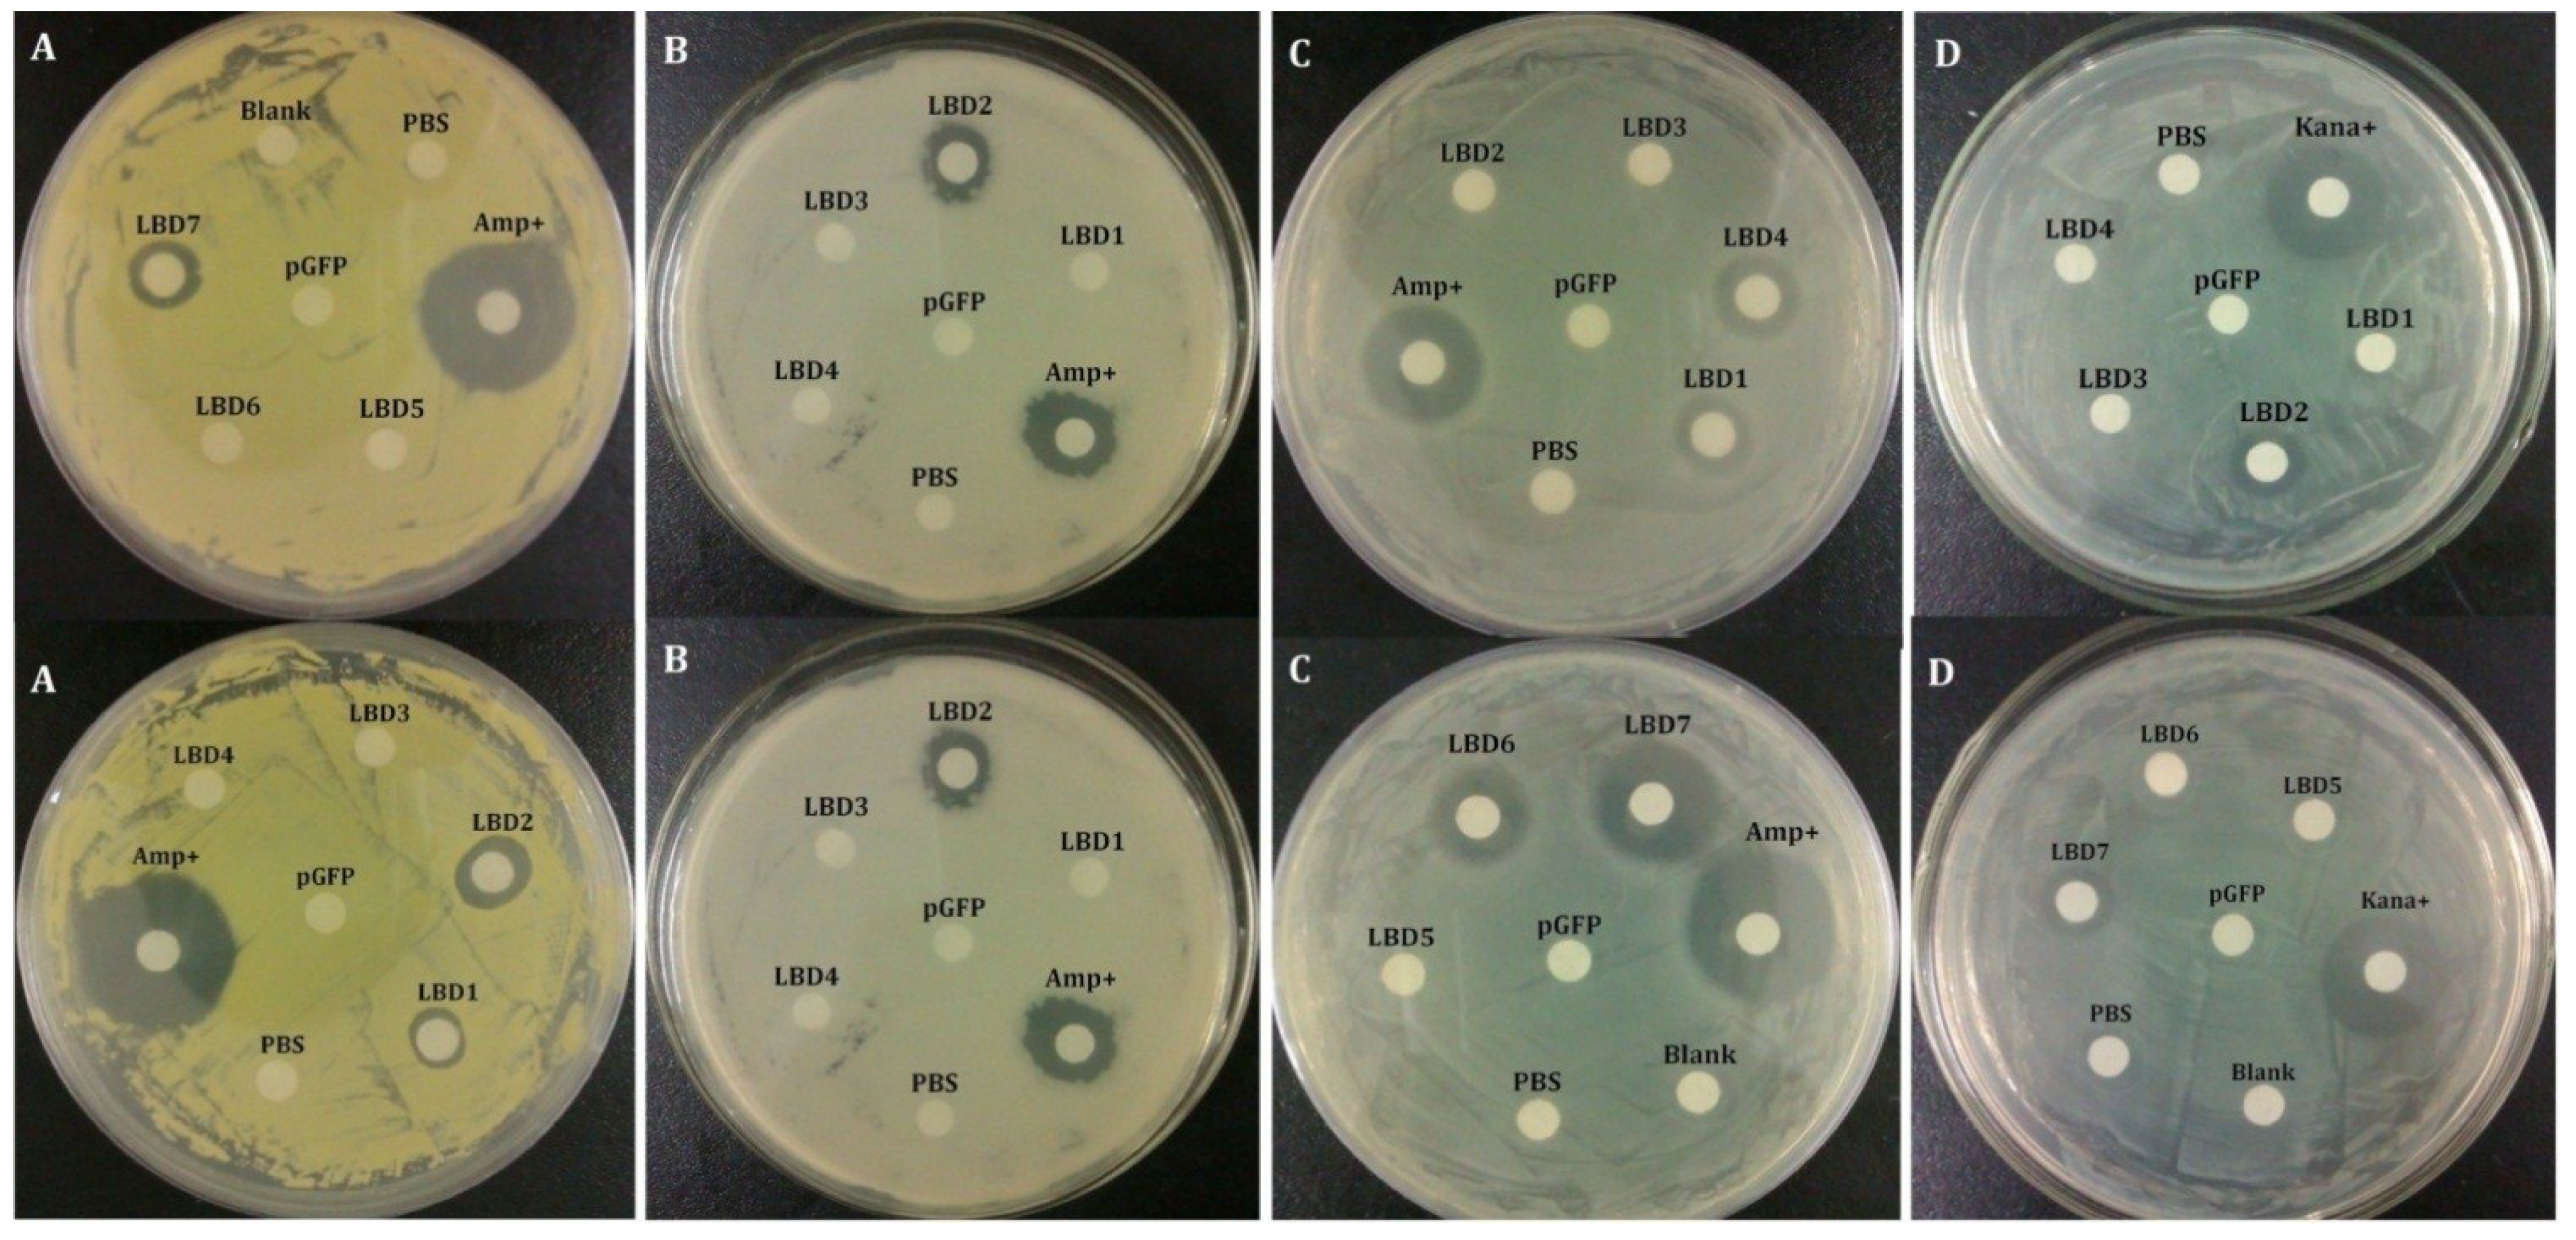
Marinedrugs 13 02602 g002

Functional Diversity of Anti-Lipopolysaccharide Factor Isoforms in Shrimp and Their Characters Related to Antiviral Activity
Abstract
:1. Introduction
2. Results
2.1. Tissue Distribution of Different FcALFs Transcripts

2.2. Antibacterial Activities of Synthetic LBD Peptides
| Bacteria | MIC Range (μM) | ||||||
|---|---|---|---|---|---|---|---|
| LBD1 | LBD2 | LBD3 | LBD4 | LBD5 | LBD6 | LBD7 | |
| M. luteus | 16–32 | 2–4 | >64 | >64 | >64 | >64 | 1–2 |
| B. simplex | >64 | 1–2 | >64 | >64 | 16–32 | >64 | 32–64 |
| E. coli | 16–32 | >64 | >64 | 8–16 | >64 | 16–32 | 32–64 |
| A. hydrophila | >64 | 32–64 | >64 | >64 | >64 | >64 | 2–4 |
2.3. Effects of Synthetic LBD Peptides of FcALFs on WSSV Infection
2.5. Effects of Modified LBD Peptides on WSSV Infection

3. Discussions
4. Materials and Methods
4.1. Animal and Tissue Collection
4.2. Total RNA Extraction, cDNA Synthesis and qPCR Analysis
4.3. Multiple Alignments of Synthetic LBD Peptides
| Gene | Primer Name | Sequence (5′–3′) | Annealing Temperature (°C) |
|---|---|---|---|
| FcALF1 | FcALF1-qF | ATGTCCTGCCCGTCCCTTAG | 59 |
| FcALF1-qR | CCTCCGTTATCACGCCCTGT | ||
| FcALF2 | FcALF2-qF | TGCGAGTGTCAGTCTTTAGC | 61 |
| FcALF2-qR | CAATCCTGTGAGTTTGTCCG | ||
| FcALF3 | FcALF3-qF | CAGGATTGTGGGAGACGGGA | 61 |
| FcALF3-qR | CTGCTGCGTGTTTCGGCTAC | ||
| FcALF4 | FcALF4-qF | ACGATGCGAGTCTTGGTCAG | 59 |
| FcALF4-qR | CTCATCCGAGTGCCACAACC | ||
| FcALF5 | FcALF5-qF | GCTTGTTGAGTCGCAGTCCT | 59 |
| FcALF5-qR | GAGCCTGTCTTATGAAATCCTT | ||
| FcALF6 | FcALF6-qF | AGACTTATGGAGGAACGGAGAC | 60 |
| FcALF6-qR | ATTTGCTGCGGGTGTTGGAC | ||
| ALFFc | ALFFc-qF | AAGCCTGGTGCTGGTGGTGT | 59 |
| ALFFc-qR | GAGTTCGGTTTTCTCGTTCCT | ||
| 18S rRNA | 18S-qF | TATACGCTAGTGGAGCTGGAA | 56 |
| 18S-qR | GGGGAGGTAGTGACGAAAAAT |
4.4. Synthesis of Different LBD Peptides of FcALF Isoforms
4.5. Inhibition Zone Test
| Gene Name | Accession Number | Peptide Name | Sequence |
|---|---|---|---|
| FcALF1 | JX853774 | LBD1 | Ac-Q(CTYSVTPTVKSFELYFKGRMSC)P-NH2 |
| FcALF2 | JX853775 | LBD2 | Ac-Y(CSFNVTPKFKRWQLYFRGRMWC)P-NH2 |
| FcALF3 | JX853776 | LBD3 | Ac-Y(CVYSVKPTFQRWQLYFIGSMWC)P-NH2 |
| FcALF4 | JX853777 | LBD4 | Ac-S(CRYSQRPSFYRWELYFNGRMWC)P-NH2 |
| FcALF5 | JX853778 | LBD5 | Ac-Y(CLLSRSPYLKKLEVHYRAELKC)P-NH2 |
| FcALF6 | JX853779 | LBD6 | Ac-S(CSYSVKPDIQGFELYFIGSVTC)P-NH2 |
| ALFFc | AY859500 | LBD7 | Ac-E(CKFTVKPYIKRFQLYYKGRMWC)P-NH2 |
| / | / | LBD2-K | Ac-Y(CSFNVTPKFQRWQLYFRGRMWC)P-NH2 |
| / | / | sLBD2 | Ac-FKRWQLYFRG-NH2 |
| / | / | LBD4+K | Ac-S(CRYSQRPSFKRWELYFNGRMWC)P-NH2 |
| GFP | AAN41637 | pGFP | Ac-TTGKLPVPWPTLVTTFSYGVQCFS-NH2 |
4.6. Minimal Inhibitory Concentration (MIC) Assay
4.8. Statistical Analysis
Acknowledgments
Author Contributions
Conflicts of Interest
References
- Morita, T.; Ohtsubo, S.; Nakamura, T.; Tanaka, S.; Iwanaga, S.; Ohashi, K.; Niwa, M. Isolation and biological-activities of limulus anticoagulant (anti-LPS factor) which interacts with lipopolysaccharide (LPS). J. Biochem. 1985, 97, 1611–1620. [Google Scholar]
- Tanaka, S.; Nakamura, T.; Morita, T.; Iwanaga, S. Limulus Anti-LPS Factor: An anticoagulant which inhibits the endotoxin-mediated activation of limulus coagulation system. Biochem. Biophys. Res. Commun. 1982, 105, 717–723. [Google Scholar] [CrossRef]
- De la Vega, E.; O’Leary, N.A.; Shockey, J.E.; Robalino, J.; Payne, C.; Browdy, C.L.; Warr, G.W.; Gross, P.S. Anti-lipopolysaccharide factor in Litopenaeus vannamei (LvALF): A broad spectrum antimicrobial peptide essential for shrimp immunity against bacterial and fungal infection. Mol. Immunol. 2008, 45, 1916–1925. [Google Scholar]
- Liu, Y.; Cui, Z.X.; Luan, W.S.; Song, C.W.; Nie, Q.; Wang, S.Y.; Li, Q.Q. Three isoforms of anti-lipopolysaccharide factor identified from eyestalk cDNA library of swimming crab Portunus trituberculatus. Fish Shellfish Immunol. 2011, 30, 583–591. [Google Scholar] [CrossRef] [PubMed]
- Liu, Y.; Cui, Z.X.; Li, X.H.; Song, C.W.; Li, Q.Q.; Wang, S.Y. Molecular cloning, expression pattern and antimicrobial activity of a new isoform of anti-lipopolysaccharide factor from the swimming crab Portunus trituberculatus. Fish Shellfish Immunol. 2012, 33, 85–91. [Google Scholar] [CrossRef] [PubMed]
- Liu, Y.; Cui, Z.X.; Li, X.H.; Song, C.W.; Shi, G.H. A newly identified anti-lipopolysaccharide factor from the swimming crab Portunus trituberculatus with broad spectrum antimicrobial activity. Fish Shellfish Immunol. 2013, 34, 463–470. [Google Scholar] [CrossRef] [PubMed]
- Supungul, P.; Klinbunga, S.; Pichyangkura, R.; Hirono, I.; Aoki, T.; Tassanakajon, A. Antimicrobial peptides discovered in the black tiger shrimp Penaeus monodon using the EST approach. Dis. Aquat. Organ. 2004, 61, 123–135. [Google Scholar] [CrossRef] [PubMed]
- Zhang, Y.; Wang, L.; Wang, L.; Yang, J.; Gai, Y.; Qiu, L.; Song, L. The second anti-lipopolysaccharide factor (EsALF-2) with antimicrobial activity from Eriocheir sinensis. Dev. Comp. Immunol. 2010, 34, 945–952. [Google Scholar] [CrossRef] [PubMed]
- Somboonwiwat, K.; Marcos, M.; Tassanakajon, A.; Klinbunga, S.; Aumelas, A.; Romestand, B.; Gueguen, Y.; Boze, H.; Moulin, G.; Bachere, E. Recombinant expression and anti-microbial activity of anti-lipopolysaccharide factor (ALF) from the black tiger shrimp Penaeus monodon. Dev. Comp. Immunol. 2005, 29, 841–851. [Google Scholar] [CrossRef] [PubMed]
- Carriel-Gomes, M.C.; Kratz, J.M.; Barracco, M.A.; Bachere, E.; Barardi, C.R.M.; Simoes, C.M.O. In vitro antiviral activity of antimicrobial peptides against herpes simplex virus 1, adenovirus, and rotavirus. Mem. Inst. Oswaldo Cruz 2007, 102, 469–472. [Google Scholar] [CrossRef] [PubMed]
- Tharntada, S.; Ponprateep, S.; Somboonwiwat, K.; Liu, H.; Söderhäll, I.; Söderhäll, K.; Tassanakajon, A. Role of anti-lipopolysaccharide factor from the black tiger shrimp, Penaeus monodon, in protection from white spot syndrome virus infection. J. Gen. Virol. 2009, 90, 1491–1498. [Google Scholar] [CrossRef]
- Liu, H.P.; Jiravanichpaisal, P.; Soderhall, I.; Cerenius, L.; Soderhall, K. Antilipopolysaccharide factor interferes with white spot syndrome virus replication in vitro and in vivo in the crayfish Pacifastacus leniusculus. J. Virol. 2006, 80, 10365–10371. [Google Scholar] [CrossRef] [PubMed]
- Hoess, A.; Watson, S.; Siber, G.R.; Liddington, R. Crystal-structure of an endotoxin-neutralizing protein from the horseshoe-crab, limulus anti-LPS factor, at 1.5 angstrom resolution. EMBO J. 1993, 12, 3351–3356. [Google Scholar] [PubMed]
- Somboonwiwat, K.; Bachere, E.; Rimphanitchayakit, V.; Tassanakajon, A. Localization of anti-lipopolysaccharide factor (ALFPm3) in tissues of the black tiger shrimp, Penaeus monodon, and characterization of its binding properties. Dev. Comp. Immunol. 2008, 32, 1170–1176. [Google Scholar] [CrossRef] [PubMed]
- Yang, Y.; Boze, H.; Chemardin, P.; Padilla, A.; Moulin, G.; Tassanakajon, A.; Pugnière, M.; Roquet, F.; Destoumieux-Garzón, D.; Gueguen, Y. NMR structure of rALF-Pm3, an anti-lipopolysaccharide factor from shrimp: Model of the possible lipid A-binding site. Biopolymers 2009, 91, 207–220. [Google Scholar] [CrossRef] [PubMed]
- Hancock, R.E.W.; Piers, K.; Brown, M.; Falla, T.; Gough, M.; Wu, M.H.; Fidai, S. Cationic peptides: A class of antibiotics able to access the self-promoted uptake pathway across the Pseudomonas aeruginosa outer membrane. In Molecular Biology of Pseudomonads; Nakazawa, T., Furukawa, K., Haas, D., Silver, S., Eds.; ASM Press: Washington, DC, USA, 1996; pp. 441–450. [Google Scholar]
- Imjongjirak, C.; Amparyup, P.; Tassanakajon, A.; Sittipraneed, S. Antilipopolysaccharide factor (ALF) of mud crab Scylla paramamosain: Molecular cloning, genomic organization and the antimicrobial activity of its synthetic LPS binding domain. Mol. Immunol. 2007, 44, 3195–3203. [Google Scholar] [CrossRef]
- Nagoshi, H.; Inagawa, H.; Morii, K.; Harada, H.; Kohchi, C.; Nishizawa, T.; Taniguchi, Y.; Uenobe, M.; Honda, T.; Kondoh, M.; et al. Cloning and characterization of a LPS-regulatory gene having an LPS binding domain in kuruma prawn Marsupenaeus japonicus. Mol. Immunol. 2006, 43, 2061–2069. [Google Scholar] [CrossRef] [PubMed]
- Rosa, R.D.; Stoco, P.H.; Barracco, M.A. Cloning and characterisation of cDNA sequences encoding for anti-lipopolysaccharide factors (ALFs) in Brazilian palaemonid and penaeid shrimps. Fish Shellfish Immunol. 2008, 25, 693–696. [Google Scholar] [CrossRef] [PubMed]
- Sharma, S.; Yedery, R.D.; Patgaonkar, M.S.; Selvaakumar, C.; Reddy, K.V. Antibacterial activity of a synthetic peptide that mimics the LPS binding domain of Indian mud crab, Scylla serrata anti-lipopolysaccharide factor (SsALF) also involved in the modulation of vaginal immune functions through NF-κB signaling. Microb. Pathog. 2011, 50, 179–191. [Google Scholar] [CrossRef] [PubMed]
- Pan, C.Y.; Chao, T.T.; Chen, J.C.; Chen, J.Y.; Liu, W.C.; Lin, C.H.; Kuo, C.M. Shrimp (Penaeus monodon) anti-lipopolysaccharide factor reduces the lethality of Pseudomonas aeruginosa sepsis in mice. Int. Immunopharmacol. 2007, 7, 687–700. [Google Scholar] [CrossRef] [PubMed]
- Guo, S.Y.; Li, S.H.; Li, F.H.; Zhang, X.J.; Xiang, J.H. Modification of a synthetic LPS-binding domain of anti-lipopolysaccharide factor from shrimp reveals strong structure-activity relationship in their antimicrobial characteristics. Dev. Comp. Immunol. 2014, 45, 227–232. [Google Scholar] [CrossRef] [PubMed]
- Li, S.H.; Guo, S.Y.; Li, F.H.; Xiang, J.H. Characterization and function analysis of an anti-lipopolysaccharide factor (ALF) from the Chinese shrimp Fenneropenaeus chinensis. Dev. Comp. Immunol. 2014, 46, 349–355. [Google Scholar] [CrossRef] [PubMed]
- Liu, Y.; Cui, Z.X.; Li, X.H.; Song, C.W.; Li, Q.Q.; Wang, S.Y. A new antilipopolysaccharide factor isoform (PtALF4) from the swimming crab Portunus trituberculatus exhibited structural and functional diversity of ALFs. Fish Shellfish Immunol. 2012, 32, 724–731. [Google Scholar] [CrossRef] [PubMed]
- Liu, Y.; Cui, Z.X.; Li, X.H.; Song, C.W.; Shi, G.H.; Wang, C.L. Molecular cloning, genomic structure and antimicrobial activity of PtALF7, a unique isoform of anti-lipopolysaccharide factor from the swimming crab Portunus trituberculatus. Fish Shellfish Immunol. 2013, 34, 652–659. [Google Scholar] [CrossRef] [PubMed]
- Li, S.H.; Zhang, X.J.; Sun, Z.; Li, F.H.; Xiang, J.H. Transcriptome analysis on Chinese shrimp Fenneropenaeus chinensis during WSSV acute infection. PLoS ONE 2013, 8, e58627. [Google Scholar] [CrossRef] [PubMed]
- Liu, F.S.; Liu, Y.C.; Li, F.H.; Dong, B.; Xiang, J.H. Molecular cloning and expression profile of putative antilipopolysaccharide factor in Chinese shrimp (Fenneropenaeus chinensis). Mar. Biotechnol. 2005, 7, 600–608. [Google Scholar] [CrossRef] [PubMed]
- Yu, Y.; Xu, T.; Yu, Y.T.; Hao, P.; Li, X. Association of tissue lineage and gene expression: Conservatively and differentially expressed genes define common and special functions of tissues. BMC Bioinform. 2010, 11, S1. [Google Scholar] [CrossRef]
- Pongsomboon, S.; Wongpanya, R.; Tang, S.; Chalorsrikul, A.; Tassanakajon, A. Abundantly expressed transcripts in the lymphoid organ of the black tiger shrimp, Penaeus monodon, and their implication in immune function. Fish Shellfish Immunol. 2008, 25, 485–493. [Google Scholar] [CrossRef]
- Van De Braak, C.B.; Botterblom, M.H.A.; Taverne, N.; van Muiswinkel, W.B.; Rombout, J.; van der Knaap, W.P.W. The roles of haemocytes and the lymphoid organ in the clearance of injected Vibrio bacteria in Penaeus monodon shrimp. Fish Shellfish Immunol. 2002, 13, 293–309. [Google Scholar] [CrossRef]
- Hasson, K.W.; Lightner, D.V.; Mohney, L.L.; Redman, R.M.; White, B.M. Role of lymphoid organ spheroids in chronic Taura syndrome virus (TSV) infections in Penaeus vannamei. Dis. Aquat. Organ. 1999, 38, 93–105. [Google Scholar] [CrossRef]
- Johansson, M.; Keyser, P.; Sritunyalucksana, K.; Söderhäll, K. Crustacean haemocytes and haematopoiesis. Aquaculture 2000, 191, 45–52. [Google Scholar] [CrossRef]
- Okumura, T.; Nagai, F.; Yamamoto, S.; Yamano, K.; Oseko, N.; Inouye, K.; Oomura, H.; Sawada, H. Detection of white spot syndrome virus from stomach tissue homogenate of the kuruma shrimp (Penaeus japonicus) by reverse passive latex agglutination. J. Virol. Methods 2004, 119, 11–16. [Google Scholar] [CrossRef] [PubMed]
- Keller, R. Crustacean neuropeptides: Structures, functions and comparative aspects. Experientia 1992, 48, 439–448. [Google Scholar] [CrossRef] [PubMed]
- Liu, L.J.; Chen, Y.J.; Chang, Y.S.; Lee, C.Y. Neuroendocrine responses of a crustacean host to viral infection: Effects of infection of white spot syndrome virus on the expression and release of crustacean hyperglycemic hormone in the crayfish Procambarus clarkii. Comp. Biochem. Physiol. A Mol. Integr. Physiol. 2013, 164, 327–332. [Google Scholar] [CrossRef] [PubMed]
- Rodriguez, J.; Boulo, V.; Mialhe, E.; Bachere, E. Characterization of shrimp hemocytes and plasma components by monoclonal-antibodies. J. Cell Sci. 1995, 108, 1043–1050. [Google Scholar] [PubMed]
- Sun, Y.M.; Li, F.H.; Xiang, J.H. Analysis on the dynamic changes of the amount of WSSV in Chinese shrimp Fenneropenaeus chinensis during infection. Aquaculture 2013, 376, 124–132. [Google Scholar] [CrossRef]
- Livak, K.J.; Schmittgen, T.D. Analysis of relative gene expression data using real-time quantitative PCR and the 2−ΔΔCT Method. Methods 2001, 25, 402–408. [Google Scholar] [CrossRef] [PubMed]
- Wiegand, I.; Hilpert, K.; Hancock, R.E.W. Agar and broth dilution methods to determine the minimal inhibitory concentration (MIC) of antimicrobial substances. Nat. Protoc. 2008, 3, 163–175. [Google Scholar] [CrossRef] [PubMed]
© 2015 by the authors; licensee MDPI, Basel, Switzerland. This article is an open access article distributed under the terms and conditions of the Creative Commons Attribution license (http://creativecommons.org/licenses/by/4.0/).
Share and Cite
Li, S.; Guo, S.; Li, F.; Xiang, J. Functional Diversity of Anti-Lipopolysaccharide Factor Isoforms in Shrimp and Their Characters Related to Antiviral Activity. Mar. Drugs 2015, 13, 2602-2616. https://doi.org/10.3390/md13052602
Li S, Guo S, Li F, Xiang J. Functional Diversity of Anti-Lipopolysaccharide Factor Isoforms in Shrimp and Their Characters Related to Antiviral Activity. Marine Drugs. 2015; 13(5):2602-2616. https://doi.org/10.3390/md13052602
Chicago/Turabian StyleLi, Shihao, Shuyue Guo, Fuhua Li, and Jianhai Xiang. 2015. "Functional Diversity of Anti-Lipopolysaccharide Factor Isoforms in Shrimp and Their Characters Related to Antiviral Activity" Marine Drugs 13, no. 5: 2602-2616. https://doi.org/10.3390/md13052602
APA StyleLi, S., Guo, S., Li, F., & Xiang, J. (2015). Functional Diversity of Anti-Lipopolysaccharide Factor Isoforms in Shrimp and Their Characters Related to Antiviral Activity. Marine Drugs, 13(5), 2602-2616. https://doi.org/10.3390/md13052602
